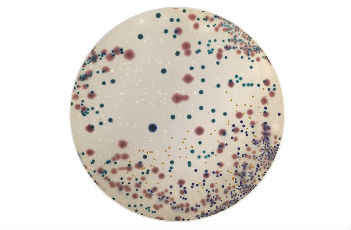

热门关键词: ELISA试剂盒 - 大鼠ELISA试剂盒- 小鼠ELISA试剂盒
全国统一客服热线:
0755-28715175
热门关键词: ELISA试剂盒 - 大鼠ELISA试剂盒- 小鼠ELISA试剂盒
全国统一客服热线:
0755-28715175

结果:
微生物(Microorganisms) | 生长情况 | 特征反应 |
产气肠杆菌 ATCC®13048 | 生长良好 | 深蓝色 |
肺炎克雷伯菌ATCC®13883 | 生长良好 | 深蓝色 |
鼠伤寒沙门氏ATCC®14028 | 生长良好 | 琥珀色(黄色) |
铜绿假单胞菌ATCC®27853 | 生长良好 | 琥珀色(黄色) |
伤寒沙门氏菌 ATCC®6539 | 生长良好 | 琥珀色(黄色) |
粪肠球菌 ATCC®19433 | 生长良好 | 浅蓝色 |
奇异变形杆菌ATCC®25933 | 生长良好 | 浅棕色 |
大肠杆菌 ATCC®25922 | 生长良好 | 粉红色 |
金黄色葡萄球ATCC®25923 | 生长良好 | (色素沉着)白色奶油状菌落 |
0755-28715175/33164177

粤公网安备 44030902000304号